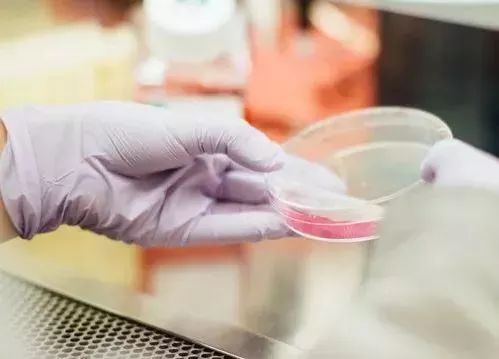

2019-06-28浏览次数:
文章来源:赋青春
(版权归原作者所有,本文仅供交流学习,部分文章推送时未能及时与原作者取得联系,若来源标注错误或侵犯到您的权益,烦请告知,我们将立即删除)
封面图片来自网络
生物技术是近年来发展最为迅猛的高新技术之一,生物序列类专利的支持性问题更是业界广为关注的问题,为了向业界传达生物技术领域的审查标准。前不久,复审和无效审理部举办了主题为“生物序列类专利支持性问题审查标准交流会”。
此次活动有针对性地选择“生物序列类专利支持性问题”作为交流主题。会上,主讲人阐述了生物序列类专利支持性判断的原则和标准,探讨了判断标准与侵权判定的关系,并结合典型和重大案例解释了判断原则和标准在实际案件中的应用。主讲人还就支持性判断与侵权判定中等同原则的关系,以及如何构建合理、稳定的权利要求体系等问题与听众进行了交流。
生物序列权利要求支持性的判断

尹昕
国家知识产权局专利局复审和无效审理部医药生物申诉二处处长,国家知识产权局知识产权培训教育类高级培养人才,二级审查员。
2012年借调最高人民法院知识产权庭。
在生物技术领域的专利授权、确权程序中,对涉及生物序列的权利要求究竟应该授予多大的保护范围,一直是世界范围内备受争议的问题。生物序列权利要求能否得到说明书支持的判断也一直是该领域专利法实践的热点和难点问题。一方面,生物技术领域研发周期长、风险大、投资成本高,因此对专利保护高度依赖,创新主体的诉求突出体现在权利要求保护范围的扩张趋势中。另一方面,该领域的研发对象是复杂的生命有机体,且在分子水平进行,可预见性较差,权利要求的保护范围受到限制。在这种情况下,使发明创造对现有技术的贡献与其获得的保护范围达到平衡,始终是该领域权利要求能否得到说明书支持的判断中应当遵循的指导思想。
与其他技术领域相比,生物序列权利要求有其鲜明的特点。首先,生物序列权利要求的限定方式多种多样。实践中很少采用单一方式,除直接限定序列本身外,一般都结合序列功能、理化特性、起源或来源、产生方法等方式进行限定。也很少有权利要求只限定单一序列,一般还采用“包含”“同源性和同一性”“变体”“杂交”等不同的术语概括权利要求的保护范围。其次,由于组成生物序列的碱基或氨基酸的可替代性和多样性,不同限定形式的权利要求囊括的生物序列往往数量巨大,给支持性的判断带来不确定因素。此外,生物序列的构效关系十分复杂,在未经验证的情况下往往难以预判。虽然在有机体中最终发挥生物学功能的是蛋白质分子,但从基因序列的转录、翻译到形成蛋白质的一级、二级、三级和四级结构的过程十分复杂,很难判断生物序列中特定位点的变化对最终功能的影响。
基于生物序列技术领域的特点,综观权利要求支持问题的审查实践,通过分析生物序列能否得到说明书支持判断标准的典型案例,该领域支持性的判断应遵循以下原则和标准。
首先,对生物序列支持问题的判断标准力求与该领域的产业、技术发展状况相适应。要充分了解现有技术状况,基于本领域技术人员具有的实验能力和分析水平考虑该领域的可预测水平,合理把握判断标准,做到“公平合理、宽严适度”,使权利要求的保护范围与其说明书公开的内容相适应,使其保护范围不超出说明书公开的范围,也不应被过分限制,以至于损害申请人应当获得的权益。
其次,应当坚持具体案情具体分析。涉及生物序列的专利申请涉及的具体技术领域、权利要求的撰写形式、要解决的技术问题、说明书公开的程度多种多样,案情错综复杂,很难有“一刀切”的判断标准。因此,在审查实践中应当针对个案的具体情况进行具体分析,对支持问题从实质上把握。例如,不能因为权利要求中出现了“包含”“同源性”等术语就认定其得不到说明书的支持,使支持性判断形式化、机械化。
第三,要客观分析权利要求保护范围的大小,这是准确判断权利要求能否得到说明书支持的基础和前提。不能忽视任何一项技术特征对权利要求要求保护范围的影响,例如同源性限定的比例大小、功能限定是否容易实现、来源或理化性质的实质限缩作用等。
第四,全面考虑说明书充分公开的内容。在判断权利要求是否能够得到说明书支持时,应分析技术背景、发明内容部分描述的总体技术方案、技术路线和技术指导、具体实施方式部分记载的验证了或者能够预见发明效果的具体实施例等内容,深入理解发明解决的技术问题及其相对于现有技术所做的改进,使其贡献与收益相一致。
最后,质疑权利要求概括的范围不能解决发明的技术问题并达到相同的技术效果时,应当有合理理由并完成初步的举证责任,但不能苛责申请人或专利权人对权利要求概括范围内的所有技术方案都进行验证。一方面,授权确权程序中专利行政部门或无效宣告请求人无法或很难对生物序列权利要求的技术方案进行试验验证,实践中有客观依据的理论说明或者举证证明都可视为对权利要求能否得到说明书支持的“合理怀疑”。另一方面,排除合理怀疑的标准不应当要求过高,因为对一项有新颖性和创造性的生物序列发明而言,很难百分之百地精确判断实施例以外的技术方案能否解决发明的技术问题。如果要求申请人或专利权人百分之百地排除一切可能性,就等同于不允许权利要求的概括超越实施例的范围。
序列变体的支持性判断

邹凯
国家知识产权局专利局复审和无效审理部医药生物申诉二处副处长,二级审查员。
2013年借调最高院知识产权庭。
生物序列类发明涉及探针、引物、抗体、酶等多个技术领域,其中,以取代、缺失或添加一定数量的核苷酸或氨基酸形式进行限定是此类发明经常采用的一种比较典型的撰写形式。这种变体类权利要求如何能够得到说明书的支持,一直是医药生物领域专利法实践中的热点和难点,也为外界广为关注。其中,涉及变体是否必须得有针对变体的实施例、组合突变能否支持单位点突变、具体位点特定突变形式能否支持该位点其他突变形式、一种突变组合方式能否支持其他组合方式等问题,都是审查实践过程中经常会碰到的。虽然这些都是与变体支持判断相关的具体问题,但这些具体问题的解答与判断权利要求能否得到说明书支持的法理基础、一般原则密切相关。
通过充分公开发明的技术方案以换取一定时间的垄断保护权是专利法中充分公开条款、权利要求应当得到说明书的支持等条款设立的法理基础。在具体的审查过程中,上述法理基础常常表现为要求发明的技术贡献与保护范围相适应。因此,准确确定发明的技术贡献是支持判断的关键点之一。
此外,在确定发明技术贡献的过程中,审查员应站在本领域技术人员的角度,通过以现有技术整体作为参照进行确定。虽然支持判断和创造性判断的具体判断内容不同,但判断主体是相同的。因此,在涉及系列相关案件的审查时,不宜出现创造性判断过程中,判断主体无所不能,而在支持的判断过程中,判断主体又退化成无任何一技之长的自相矛盾的情形。
在保证判断主体准确定位的基础上,需要以发明的技术贡献为核心,通过综合考虑发明的贡献、变体突变位点和突变方式的代表性、系列案件的情况、现有技术的整体情况等因素来进行判断。例如在第38461号无效决定中,合议组认为,涉案专利已经公开了L417V、T430A或N563I这三种单突变形式,也公开了包含上述突变的数量众多的组合突变,包括包含上述三个具体突变的多个组合突变,所述系列变体整体都呈现出酶性能的改善。基于此,本领域技术人员能够合理预期L417V、T430A和N563I突变与酶稳定性能之间具有相关性,因此,虽然说明书中没有公开仅含有L417V、T430A和N563I突变的组合变体的实验数据,但本领域技术人员基于申请文件的整体教导能够合理预期仅具体所述三个突变的变体也将具有改善的性能。同时,合议组在第38456号无效决定所涉及的系列案件中认定,在针对同一位点采用相同方式的单突变、其他组合突变已经被公开的情况下,本领域技术人员有动机尝试其他组合方式,这种将系列案件进行整体综合考量的方式保证了创造性与支持判断逻辑的一致性。此外,在第63698号复审决定中,合议组认为,发明的权利要求保护的一种制药用途,从说明书记载的内容来看,发明的技术贡献在于发现已知肽的新用途,而不是为了制备得到具有新性能的变体。在现有技术的参考文献已经记载了多个具体的变体,并揭示了所述肽的功能结构域的基础上,本领域技术人员能够确定在哪些位点进行何种方式的改变能够制备得到具有相同或类似活性的变体。此外,说明书已经验证多肽本身具备刺激软骨细胞增生的活性,在此基础上,本领域技术人员能够预期相应的酶变体也将具备类似的治疗活性。因此,虽然说明书中未对变体进行试验,但采用“一个或多个取代方式”进行限定的变体所涉及的技术方案也能够得到说明书的支持。
综上可见,序列变体的支持性判断需要遵循支持判断的一般原则和思路,在具体的判断过程中,则需要以准确确定发明的实际技术贡献为中心,综合考虑多个因素进行判断。
文章来源:赋青春